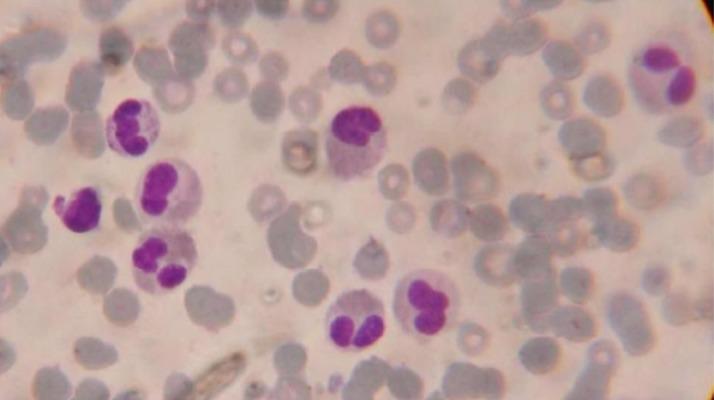
https://cdn.ncbi.nlm.nih.gov/pmc/blobs/1054/3715333/3612cbfe526a/amjcaserep-14-143-g001.jpg

急性淋巴细胞白血病的嗜酸性表现
Eosinophilic presentation of acute lymphoblastic leukemia.
作者信息
Rezamand Azim, Ghorashi Ziaaedin, Ghorashi Sona, Nezami Nariman
机构信息
Department of Pediatrics, Tabriz University (Medical Sciences), Tabriz, Iran.
出版信息
Am J Case Rep. 2013 May 8;14:143-6. doi: 10.12659/AJCR.883905. Print 2013.
PATIENT
Male, 5 Primary Diagnosis: Rule-out appendicitis Co-existing Diseases: Acute lymphoblastic leukemia (ALL) Medication: Chemiotherapy Clinical Procedure: Chest CT • flow cytometry Specialty: Pediatrics' oncology • infection diseases.
OBJECTIVE
Rare disease.
BACKGROUND
Leukemias are among the most common childhood malignancies. Acute lymphoblastic leukemia (ALL) accounts for 77% of all leukemias. In rare cases, ALL patients may present with eosinophilia.
CASE REPORT
Here, a 5-year old boy was admitted to our hospital with a possible diagnosis of appendicitis. This patient's complete blood cell count demonstrated leukocytosis with severe eosinophilia. Following a 1-month clinical investigation, 2 bone marrow aspirations, and flow cytometry analysis, a diagnosis of acute lymphoblastic leukemia was proposed. Finally, the patient was transferred to the oncology ward to receive standard therapeutic protocol, which resulted in disease remission. After chemotherapy for 2 years, patient is successfully treated.
CONCLUSIONS
ALL is diagnosed by eosinophilia in rare cases. These patients need immediate diagnosis and intensive therapy due to worsened prognosis of ALL presenting as hypereosinophilia.
患者
男性,5岁
初步诊断
排除阑尾炎
并存疾病
急性淋巴细胞白血病(ALL)
用药情况
化疗
临床检查
胸部CT • 流式细胞术
专业领域
儿科肿瘤学 • 感染性疾病
目的
罕见病
背景
白血病是儿童期最常见的恶性肿瘤之一。急性淋巴细胞白血病(ALL)占所有白血病的77%。在罕见情况下,ALL患者可能出现嗜酸性粒细胞增多。
病例报告
在此,一名5岁男孩因可能诊断为阑尾炎入住我院。该患者的全血细胞计数显示白细胞增多伴严重嗜酸性粒细胞增多。经过1个月的临床调查、2次骨髓穿刺和流式细胞术分析,提出了急性淋巴细胞白血病的诊断。最后,患者被转入肿瘤科病房接受标准治疗方案,病情缓解。化疗2年后,患者成功治愈。
结论
罕见情况下,ALL可通过嗜酸性粒细胞增多来诊断。由于以嗜酸性粒细胞增多为表现的ALL预后较差,这些患者需要立即诊断并进行强化治疗。